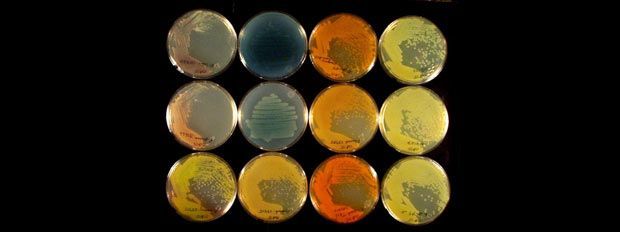
Drugs from dirt wsu edu

Drugs from Dirt is a project looking for the drugs and medicines of the future. It's trying to find the next generation of anti-cancer drugs and antibiotics by examining soil samples collected from all over the world.
Drugs from Dirt is a project looking for the drugs and medicines of the future. It's trying to find the next generation of anti-cancer drugs and antibiotics by examining soil samples collected from all over the world.